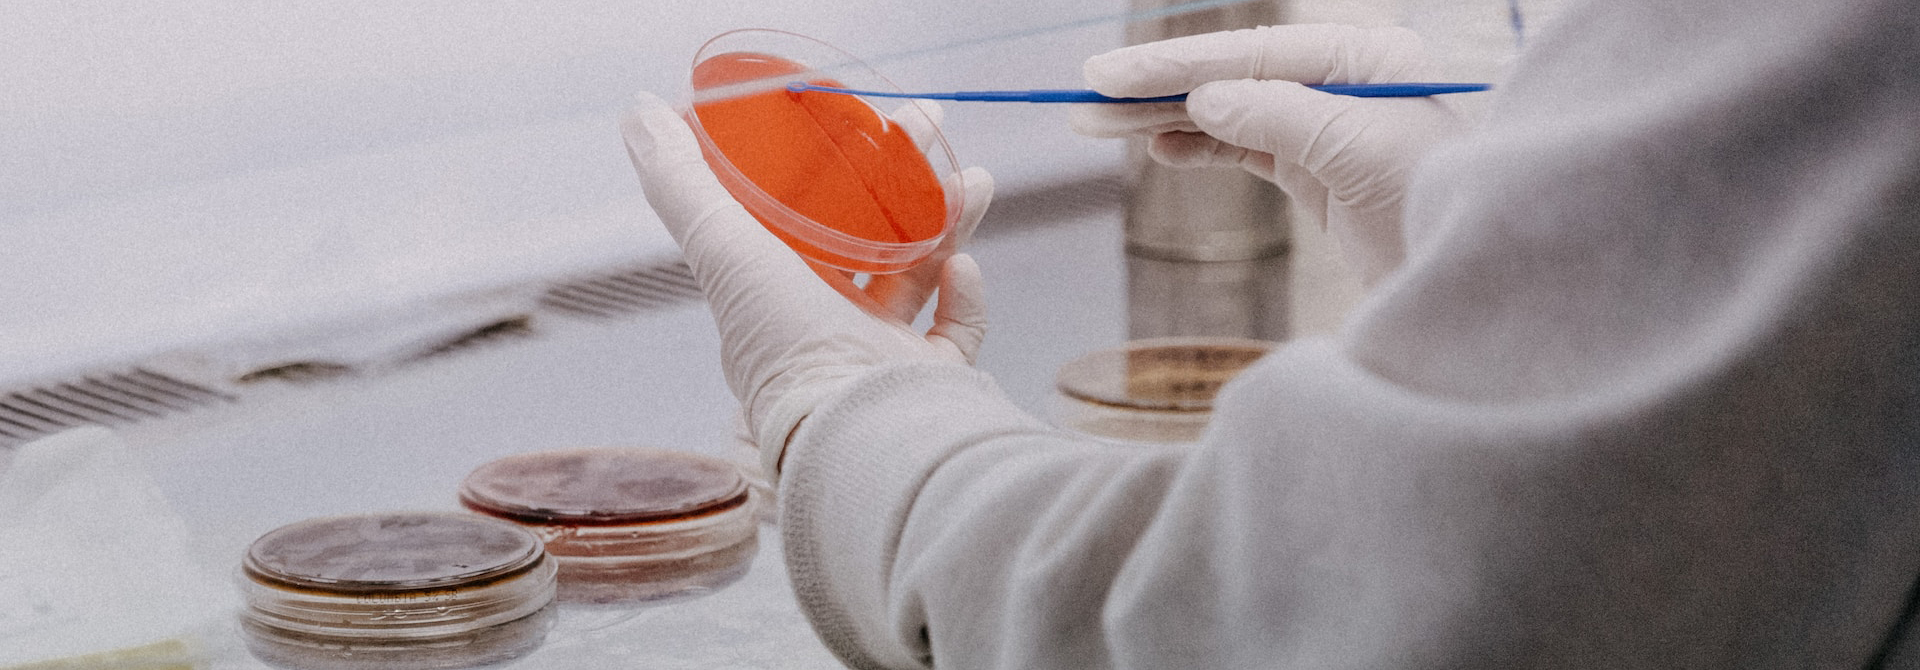

About us
LaBESTA
The Laboratory of Molecular Biology, Epidemiology, and Surveillance of Bacteria and Viruses Transmitted through Food and Water (LaBESTA), led by Professor Nicolas BARRO, at the Faculty of Life and Earth Sciences, Department of Biochemistry Microbiology, is a research laboratory at Joseph KI-ZERBO University. Its objectives are focused on food and public health. LaBESTA consists of three teams :
- The BioPathogens/Bioinformatics (Bio-Pathos/Bio-I) team, led by Professor Nicolas BARRO, director of LaBESTA.
- The Human Nutrition, Food Technology, and Toxicology (NuHTTA) team, led by Dr. Philippe Augustin NIKIEMA.
- The Food and Biomolecules (AliBiom) team, led by Professor Imaël Henri Nestor BASSOLE.
UGenoPath One Health
The One Health Pathogen Genomics Unit (UGenoPath-OH) is a unit within LaBESTA, a research laboratory based at Joseph KI-ZERBO University. UGenoPath's main mission is research development and training in Burkina Faso and Africa. Its ambition is to establish itself as a national and sub-regional reference center for research in health, environment, food safety, and animal health, following the One Health approach.
- UGenoPath-OH is led by Professor Isidore BONKOUNGOU.
Expertise and training in :
- Biosafety and quality management
- Environmental control and food safety
- Molecular Biology/Genomics and Bioinformatics
Our mission
What is our mission?
Epidemiological surveillance mission
The main mission of the UGenoPath-OH unit is to ensure epidemiological surveillance of bacteria and viruses transmitted through water and food. Achieving this mission involves :


The LaBESTA Team
Directeur du LaBESTA
Responsable de l'UGenoPath
Responsable de l'Equipe NuHTTA
Responsable de l'Equipe AliBiom